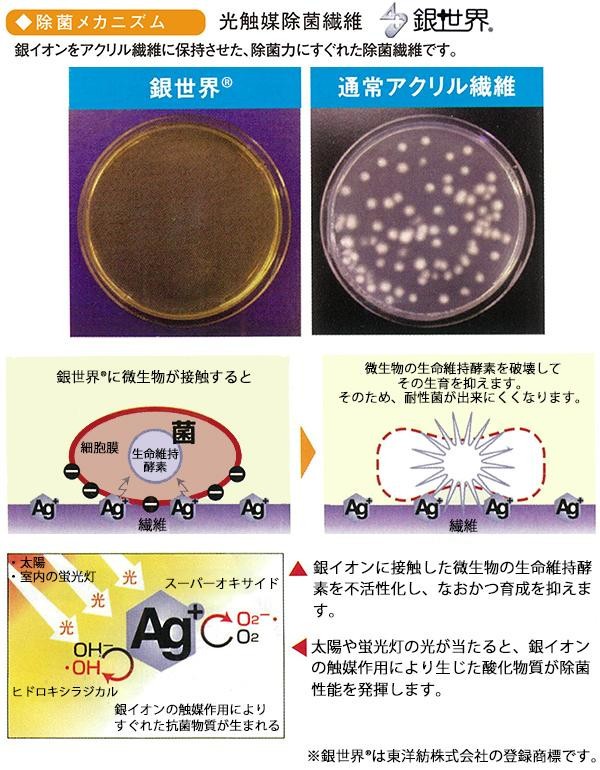

| 除菌繊維を使用したペット用エアークッションマット!! |

|
弾力性のあるマットが室内運動によるペットの股関節への衝撃を和らげます。静電気が発生しにくいのでごみやホコリが付きにくく、また、除菌と吸水効果で室内を快適に保ちます。 |
fk094igrjs
| 弾力性のあるマットが室内運動によるペットの股関節への衝撃を和らげます。静電気が発生しにくいのでごみやホコリが付きにくく、また、除菌と吸水効果で室内を快適に保ちます。 |
| サイズ | 90×60cm 個装サイズ:46×31×3cm |
| 重量 | 個装重量:680g |
| 素材・材質 | 表面:東洋紡銀世界・QX(R)(吸水、静電繊維) 裏面:ホットメルト 刺繍糸:ポリエステル |
| 仕様 | 手洗い推奨、脱水機使用可、乾燥機使用不可 |
| 製造国 | 日本 |